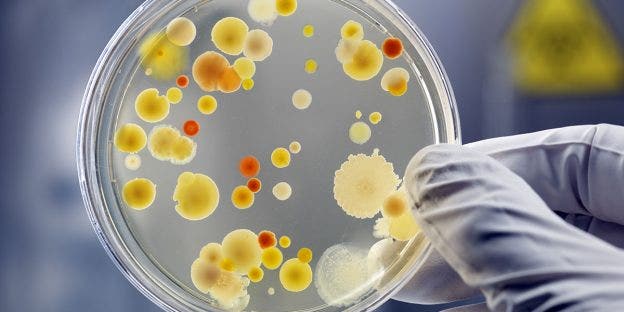

Empowering microbial biotechnology to address global challenges
Researchers working across diverse areas are increasingly turning to innovative biotechnologies to address global challenges, from food security to the need for greener fuel alternatives. For instance, biotechnology plays a pivotal role in crop improvement through genetic engineering, resulting in pest-resistant and drought-tolerant plants with greater yields. It can also be used to optimize the production and manufacture of food and beverages to reduce overhead costs for greater profit margins. Similarly, industrial and synthetic biotechnology are being employed to produce sustainable biomaterials, biofuels, and specialty chemicals, reducing our reliance on fossil fuels. Meanwhile, environmental biotechnology applications focus on the use of microorganisms for wastewater treatment and bioremediation of polluted sites, contributing to ecological restoration. In the pharmaceutical space, microbial biotechnology is important for developing alternative ingredients used in biologics and chemical compounds, potentially improving efficacy and yields.
Cell sorting has traditionally been viewed as a staple in the fields of human health and clinical diagnostics but, in recent years, its role in biotechnology applications has been growing. This is because it allows researchers to rapidly identify cells with desirable traits or characteristics within a large population, and to carry out cell analysis as a way of monitoring ongoing processes, such as determining microbial viability and robustness during process development. Important in this respect, cell sorting’s capacity for high throughput screening and rapid evaluation of a vast number of cells can save valuable time and simultaneously conserve reagents and financial resources.
For example, the fast and accurate selection of cells with particular genetic markers is paramount to the success of genetic engineering projects. Likewise, cell sorting can also be employed iteratively during the engineering process to isolate the top-performing variants and continually improve a strain’s expression of certain key traits over time. It is no surprise then that researchers rely on it in daily workflows for continuous monitoring of microorganism health and activity during fermentation, and to quickly determine whether production levels have dropped due to emerging mutations.
Versatility for every application
Choosing the right cell sorter can help to streamline and optimize both existing and novel development processes, and frees up funding for other vital aspects of research. The SH800 Cell Sorter is a highly flexible and easy-to-use instrument that performs precise sorting, characterization, and isolation of cells and microorganisms with desired properties across a wide range of biotechnology applications. This intuitive and user-friendly platform can be equipped with a microfluidic chip—available in 70-μm, 100-μm and 130-μm options—to offer rapid processing for a range of cell types, while exerting minimal shear stress and mechanical forces on cells during sorting. Gentle sorting ensures the preservation of cell viability and integrity, which is crucial when performing downstream studies that require the use of intact cells and the accurate determination of sample viability.
For example, intact cells are crucial for reliably assessing the number of live microorganisms used in fermentation procedures when inoculating wine or beer with yeast. The system and chips are also engineered with contamination prevention in mind, and chips and fluidic lines can easily be exchanged between runs to prevent cross-contamination, making this setup well suited to microbiology applications demanding high purity. Additionally, the SH800 reduces reagent consumption and enhances overall sorting efficiency when compared to traditional methods, allowing researchers to reduce their consumables expenditure.
Precise cell analysis for efficient fermentation
The exceptional sensitivity of the SH800 is particularly advantageous in bacterial applications, because it enables users to accurately detect and isolate small cells. The platform has therefore become a valuable tool in studies involving lactic acid bacteria.1 These bacteria are heavily used as starters in the fermentation of foods such as cheese, yogurt, wines, and meats, and can also be used as probiotics. However, the demanding environmental factors required in food processing—such as high pH, temperature, and salt concentration—can cause stress to the lactic acid bacteria, severely hindering their physiological function.2 Bacteria used as probiotics also must be able to survive challenging conditions in the gastrointestinal tract, including high acidity and enzymatic activity, to confer promised health benefits.3 These factors highlight the essential role of precise quantitative assessment of cell viability with the SH800 to determine stress response.
Characterizing performance for higher yields
Cell analyzers also play a crucial role in biotechnology applications involving yeast. Yeast cells continually adapt their metabolism to changing medium conditions, and adaptation is dependent on proper cell function. Various parameters, including membrane potential, storage products such as glycogen, trehalose, and neutral lipids, and mitochondrial activity and DNA integrity, are key indicators of functionality and can be efficiently evaluated with a cell analyzer. Additionally, these platforms can be used to assess factors including viability, cell cycle, intracellular pH, and reactive oxygen species, offering valuable insights into the performance of yeast populations during fermentation and bioproduction.4 High throughput cell sorters, such as the SH800, enable multiple rounds of mutagenesis and screening, supporting the rapid selection of novel yeast strains possessing gene deletions that boost yield.5
Cell sorting for sustainability
Microalgal biotechnology enables the development of eco-friendly solutions for food, feed, and fuel production, and could help to address issues with CO2 emissions and phosphorus use. However, high production costs limit the commercialization of this technique in niche applications, such as in the production of pigments and fatty acids. Efficient, high throughput screening is crucial for discovering novel microalgal strains with enhanced traits that will be commercially viable in larger markets. With its user-friendly design and full automation, the SH800 has already been used successfully to isolate strains with high biocomponent production capabilities and to enhance the biomass yield of photosynthesis through improved CO2 fixation in microalgae.6 The platform has also been applied to screen and isolate strains that accumulate lipids under desired conditions for commercial scale-up.7
Whatever the feedstock, the right cell sorting tools bring efficiency and precision to microbial biotechnology workflows, empowering scientists to unlock the full potential of living systems. The SH800 cell sorter from Sony stands out as a reliable, cost-effective, and highly sensitive solution for cell selection and monitoring in a vast range of applications—from sustainable agriculture to cutting-edge medicines—and is supporting researchers in making groundbreaking discoveries that could contribute to a more sustainable planet.
References
- Namai F, Sumiya S, Nomura N, Sato T, Shimosato T. Development of fluorescence-labeled antibody for immune checkpoint inhibitor using engineered probiotics. AMB Express. 2023;13:4. PubMed
- Rault A, Béal C, Ghorbal S, Ogier J-C, Bouix M. Multiparametric flow cytometry allows rapid assessment and comparison of lactic acid bacteria viability after freezing and during frozen storage. Cryobiology. 2007;55:35-43. PubMed
- Quinto E, Jiménez P, Caro I, Tejero J, Mateo J, Girbés T. Probiotic lactic acid bacteria: a review. Food and Nutrition Sciences. 2014;5:1765-1775. Scientific Research
- Sommer S. Monitoring the functionality and stress response of yeast cells using flow cytometry. Microorganisms. 2020;8:619. PubMed
- Savitskaya J, Protzko RJ, Li F-Z, Arkin AP, Dueber JE. Iterative screening methodology enables isolation of strains with improved properties for a FACS-based screen and increased L-DOPA production. Sci Rep. 2019;9:5815. PubMed
- Li D, Dong H, Cao X, Wang W, Li C. Enhancing photosynthetic CO2 fixation by assembling metal-organic frameworks on Chlorella pyrenoidosa. Nat Commun. 2023;14:5337. PubMed
- Oyama T, Kato Y, Satoh K, et al. Development of mutant microalgae that accumulate lipids under nitrate-replete conditions. Algal Research. 2021;60:102544. ScienceDirect